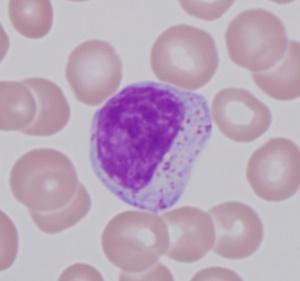

石田 文宏

教員氏名 | 石田 文宏 |
---|---|
職名 | 教授 |
所属 | 検査技術科学専攻 |
経歴 | 信州大学医学部医学科卒業 同大学院博士課程修了 信州大学医学部准教授 血液内科科長を経て、2012年から現職 骨髄不全やリンパ系腫瘍の病態解析と新規治療法開発について研究している |
腫瘍と非腫瘍の接点;その違いはどこにあるのか?
ー 血液細胞から探る ー
血液中にはさまざまな血液細胞が流れていますが、時にはそのバランスが破綻します。赤血球が足りなくなったり(=貧血)白血球が腫瘍(=白血病)になったりするのはその一例です。血液検査学および血液病学は血液細胞の異常や凝固システムの問題を検査からとらえ、その病態を把握し、背景にある疾患の診断および治療を通して、ヒトの健康の維持に貢献します。
当研究室では白血球のひとつである大型顆粒リンパ球(large granular lymphocyte; LGL)の白血病および、赤芽球癆を中心に、細胞の特性、貧血の一種である遺伝子変異、臨床的特徴や免疫異常といった多方面から解析しています。血液細胞の腫瘍と非腫瘍の違いの本質を見極めることをめざしています。
当研究室では白血球のひとつである大型顆粒リンパ球(large granular lymphocyte; LGL)の白血病および、赤芽球癆を中心に、細胞の特性、貧血の一種である遺伝子変異、臨床的特徴や免疫異常といった多方面から解析しています。血液細胞の腫瘍と非腫瘍の違いの本質を見極めることをめざしています。

血液1滴から、血液塗抹標本を作成する。血液細胞の異常を知る第一歩
研究から広がる未来
医学が進歩すると、新たな未知の領域が展開します。近年の遺伝子解析法の進歩により、腫瘍の遺伝子異常に関する詳細が明らかになり、全貌がわかるのも間近です。一方、非腫瘍性の細胞にも遺伝子異常があることが判明してきています。従来、腫瘍の特徴と考えられてきた遺伝子異常が、非腫瘍の細胞にも存在する事実は何を意味するのか? 腫瘍と非腫瘍の違いは何か? 腫瘍と遺伝子について、パラダイムシフトがおこりつつあります。
光学顕微鏡でみた大型顆粒リンパ球(LGL) (総合倍率 1,000倍)
卒業後の未来像
血液の異常にかかわる臨床検査技師や医師にとっては、AIの進歩にもかかわらず、顕微鏡でみる血液細胞の理解が必須です。そして、その背景や現象を研究し成果を世界に発信することは、未来の医療と患者さんへの還元につながります。


LGL白血病細胞に関するフローサイトメトリーによる解析(上)と 次世代シークエンサーによる遺伝子解析(下)の一例